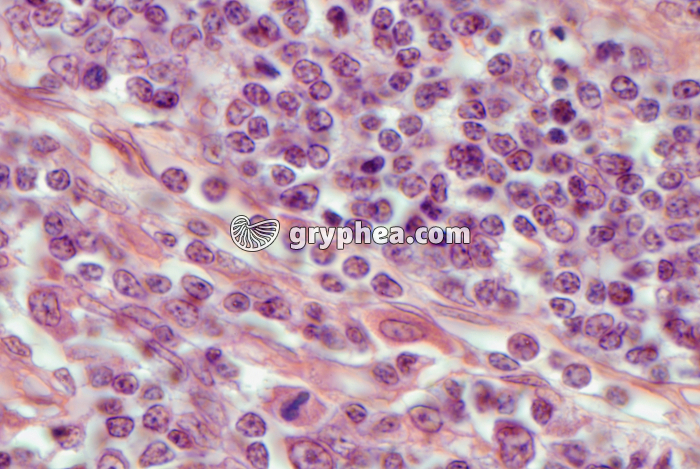
Thymus x400 - gryphea.com

1 crédit = 6.00€ TTC
(Hors pack)
si vous êtes enseignant, le site gryphea.org a été conçu spécialement pour vous !
Le thymus est un organe lymphoïde primaire, de petite taille (15 à 25g en moyenne chez l’enfant), formé de 2 lobes, et localisé à la limite entre le cou et le thorax, juste sous la thyroïde. Il atteint son maximum de développement au cours de la puberté, puis régresse imperceptiblement durant toute la vie d’adulte, pour disparaître presque complètement chez les vieillards. Cet un organe qui joue un rôle primordial dans la maturation de certaines cellules immunitaires originaires de la moelle osseuse, les lymphocytes T, qui acquièrent des récepteurs membranaires nouveaux lors de leur séjour dans l’organe.
Note : Chez le veau, le thymus, hypertrophié par rapport à celui de l’Homme, est proposé comme mets d’exception appelé «ris de veau».
La suite du commentaire est réservée aux inscrits, créez un compte gratuitement.